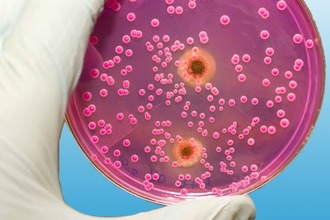
Классификация фарингомикоза бактерии

Особенности фарингомикоза
Грибковый фарингит выявляется примерно у 40% пациентов, обращающихся к отоларингологу с жалобами на дискомфорт и сухость в горле. Это инфекционное заболевание редко возникает изолированно.
Чаще всего появлению грибковой флоры в слизистой гортаноглотки предшествуют вирусные инфекции, такие как тонзиллит, грипп, ОРВИ и другие простудные заболевания.
В большинстве случаев фарингомикоз вызывается дрожжеподобными грибами, например, Candida albicans, и плесневыми, такими как Aspergillus glaucus. Развитию патогенной флоры способствуют следующие факторы:
- чрезмерное использование медикаментов — кортикостероидов, антибиотиков, цитостатиков;
- вредные привычки — курение, злоупотребление алкоголем, избыточное потребление углеводов;
- наличие хронических заболеваний — туберкулез, сахарный диабет, гипотиреоз;
- обострение хронических недугов — гнойного тонзиллита, бактериального фарингита и других.
Опасность грибкового фарингита заключается в том, что при прогрессировании патогенной флоры может развиться микоз внутренних органов или сепсис.
Как и многие другие заболевания вирусной или бактериальной природы, грибки начинают активно размножаться только при снижении иммунной реакции организма. Дрожжеподобные грибы в небольших количествах постоянно присутствуют в слизистой оболочке ЛОР-органов, и иммунные клетки контролируют их размножение. Если микрофлора в горле нарушается, количество патогенов увеличивается, что может привести к септическому воспалению мягких тканей.
Врачи отмечают, что грибковые инфекции в горле могут проявляться различными симптомами, которые важно распознавать на ранних стадиях. Одним из основных признаков является боль в горле, которая может усиливаться при глотании. Пациенты часто жалуются на ощущение сухости и дискомфорта, а также на наличие белого налета на слизистой оболочке. Врачами также подчеркивается, что такие инфекции могут сопровождаться изменением вкусовых ощущений и неприятным запахом изо рта. Важно помнить, что грибковые инфекции могут возникать на фоне ослабленного иммунитета или после длительного приема антибиотиков. Поэтому при появлении указанных симптомов рекомендуется обратиться к специалисту для диагностики и назначения адекватного лечения.

Формы фарингомикоза
Симптоматика грибкового поражения горла не является специфичной и зависит от особенностей протекания патологических процессов в дыхательных путях. Если кандидозный фарингит не будет своевременно выявлен, воспаление может перейти в хроническую форму. Выделяют две основные разновидности ЛОР-заболевания: острую и хроническую.
Грибковая инфекция, независимо от степени выраженности воспалительных процессов, в основном локализуется на задней стенке глотки, небных дужках и миндалинах. При дальнейшем развитии инфекции могут быть затронуты гортань, пищевод, носовая полость, трахея и бронхи. Важно отметить, что грибок в горле может вызвать образование абсцесса в области около миндалин.
Плесневые грибы выделяют токсичные вещества, способствующие образованию гноя в слизистых оболочках. При распаде тканей защитные клетки (лейкоциты) стремятся к очагам воспаления и формируют вокруг пораженной зоны капсулу из гранулезной ткани. Со временем гнойный экссудат, заключенный в эту капсулу, начинает увеличиваться. При самопроизвольном вскрытии абсцесса часть его содержимого может проникнуть в глубокие слои мягких тканей, что приведет к усилению воспалительного процесса и, как следствие, к стенозу гортани.
Стеноз гортани проявляется значительным сужением просвета дыхательных путей, что затрудняет поступление воздуха в трахею и легкие.
| Признак | Описание | Возможные причины (грибки) |
|---|---|---|
| Боль в горле | Может быть от легкого дискомфорта до сильной боли, особенно при глотании. | Кандида, Aspergillus |
| Изменения цвета миндалин | Белый, желтоватый или сероватый налет на миндалинах, который может быть трудно удалить. | Кандида, Aspergillus |
| Отек миндалин | Миндалины могут быть увеличены и покрасневшими. | Кандида |
| Сухость во рту | Чувство сухости и жжения во рту. | Кандида |
| Трудности при глотании | Затрудненное проглатывание пищи и слюны. | Кандида, Aspergillus |
| Изменение вкуса | Изменение или потеря вкуса. | Кандида |
| Трещины в уголках рта (заеды) | Болезненные трещины в уголках рта. | Кандида |
| Белый налет на языке | Белый налет на языке, который может быть трудно удалить. | Кандида |
| Кашель | Сухой или влажный кашель. | Aspergillus |
| Лихорадка | Повышение температуры тела. | В зависимости от тяжести инфекции и сопутствующих заболеваний |
Общие симптомы
Каковы ключевые признаки грибка в горле?
Клинические проявления кандидозного фарингита заметны, за исключением болевого синдрома. При грибковом поражении органов ЛОР пациенты отмечают умеренные боли в голове и горле, которые усиливаются при глотании слюны или во время еды.
Симптомы фарингомикоза включают:
- повышение температуры (до 38,5°C);
- жжение и дискомфорт в горле;
- ощущение инородного тела в области кадыка;
- сухость слизистой гортаноглотки;
- затруднения при глотании;
- умеренные головные боли.
При дальнейшем развитии инфекции боль в горле может отдавать в нижнюю челюсть или шею, что указывает на инфицирование регионарных лимфоузлов. Из-за интоксикации организма продуктами метаболизма плесневых и дрожжеподобных грибков у пациентов часто наблюдаются снижение аппетита, проблемы со сном, боли в животе и тошнота.
Кандидозный фарингит, если его не лечить вовремя, может привести к осложнениям, затрагивающим соматические органы, а иногда и к заражению крови.
У маленьких детей фарингомикоз протекает тяжелее, чем у взрослых. Кандидозное заболевание горла часто сопровождается микозом ротовой полости. Характерный белый налет может образовываться не только на задней стенке глотки или гландах, но и на внутренней поверхности щек. Грудные дети могут отказываться от пищи, так как грудное молоко еще больше раздражает слизистую и усиливает дискомфорт в дыхательных путях.
Грибковые инфекции в горле, такие как кандидоз, вызывают множество дискомфортных ощущений. Люди часто отмечают появление белого налета на языке и слизистой оболочке рта, что может сопровождаться зудом и жжением. Многие жалуются на боль при глотании, что затрудняет прием пищи и жидкости. Часто пациенты описывают ощущение «комка» в горле, что также вызывает тревогу. Важно отметить, что грибковые инфекции могут возникать на фоне ослабленного иммунитета, длительного приема антибиотиков или гормональных препаратов. Люди советуют не игнорировать симптомы и обращаться к врачу для диагностики и назначения адекватного лечения. Правильная гигиена полости рта и укрепление иммунной системы могут помочь в профилактике этих неприятных заболеваний.

Местные симптомы
При дискомфорте при глотании стоит проверить состояние горла. Проявления грибковой инфекции зависят от возбудителя. Характер белого налета на миндалинах, стенках глотки и небных дужках, а также выраженность симптомов зависят от типа грибка, вызвавшего воспаление слизистой.
При заболевании, вызванном дрожжеподобными грибками рода Candida, наблюдается умеренное покраснение слизистых оболочек. Основные признаки кандидозного фарингита:
- покраснение и отечность небных дужек;
- белый налет на стенках горла;
- небольшое увеличение миндалин;
- болезненность лимфоузлов под челюстью.
Внешний вид белого налета может варьироваться. У некоторых пациентов он творожистый, у других — пористый. При кандидозном воспалении ЛОР-органов налет легко удаляется медицинским шпателем. Очищенные участки слизистой могут кровоточить или покрываться мелкими язвами.
Если в горле развивается плесневой грибок, налет приобретает желтоватый оттенок. Он практически не отделяется от слизистой и в основном локализуется на задней стенке горла. Болевые ощущения при этом выражены сильнее, чем при кандидозном фарингите. Интенсивные боли могут иррадиировать в ухо с пораженной стороны или в шею.
Если не лечить фарингомикоз, в местах появления налета могут образоваться язвенно-некротические участки, которые можно будет удалить только хирургическим путем.
Спутники фарингомикоза
При обобщении патологических процессов споры грибков могут попадать в ротовую полость, что приводит к местным осложнениям. Кандидозное поражение слизистой оболочки рта и лимфатических узлов часто сопровождает фарингомикоз. Наиболее распространенные местные осложнения грибкового фарингита включают:
- Кандидомикотический ангулит (заеды) — инфекционное поражение слизистой рта и кожи в уголках губ. Это состояние проявляется образованием ярко-красных эрозий, окруженных шелушащейся кожей.
- Шейный лимфаденит — гнойное воспаление лимфатических узлов шеи и под челюстью, вызывающее болезненные ощущения при поворотах головы, разговоре и пальпации.
- Кандидозный хейлоз — грибковое поражение кожи в уголках рта, сопровождающееся образованием трещин. Эта патология возникает, когда слюна, содержащая споры грибков, попадает на кожные покровы.
Симптомы фарингомикоза могут существенно различаться у разных пациентов. У детей и беременных женщин кандидозное воспаление горла может протекать в более тяжелой форме.
При отсутствии должного лечения у таких пациентов часто возникают местные осложнения, особенно заеды вокруг рта. Если заболевание не будет своевременно диагностировано и не будет проведена антимикотическая терапия, инфекция может распространиться на кожу и привести к развитию фурункулеза.

Классификация фарингомикоза
Кандидозный фарингит часто сопровождается другими инфекциями. У около 43% пациентов одновременно выявляют риносинусит, ларингит, бронхит, тонзиллит, грипп и другие заболевания. В зависимости от клинических и морфологических проявлений грибкового воспаления в области ЛОР-органов выделяют четыре типа фарингомикоза:
- Эритематозный – на задней стенке горла появляются гладкие «лакированные» участки ярко-красного цвета, вызывающие першение, жжение или зуд.
- Псевдомембранозный – характеризуется образованием творожистого белого налета на миндалинах и стенках горла. При удалении налета могут быть обнаружены кровоточащие участки слизистой, иногда с язвами.
- Гиперпластический – в местах локализации грибков слизистая оболочка утолщается и покрывается белым пористым налетом, который трудно удалить шпателем.
- Эрозивно-язвенный – наиболее тяжелая форма заболевания, при которой на миндалинах, корне языка и небных дужках образуются кровоточащие язвы, вызывающие боль при глотании и при употреблении кислой или соленой пищи.
Грибковая флора может также поражать гортань и голосовые связки, что приводит к развитию кандидозного ларингита. Из-за интоксикации организма и аллергических реакций слизистые оболочки дыхательных путей сильно отекают. Сужение просвета в горле затрудняет дыхание, что вызывает у пациентов быструю утомляемость, плохой сон, головокружение и другие симптомы.
Фарингомикоз у детей
Низкая реактивность иммунной системы — одна из основных причин фарингомикоза у детей. Практически полное отсутствие антител против грибков способствует активному размножению условно-патогенных микроорганизмов. Заболевание часто развивается на фоне авитаминозов, особенно нехватки витамина В2 (лактофлавина).
Грибковая инфекция обычно протекает в тяжелой форме и может привести к осложнениям, если возбудителем являются плесневые грибы. Основные симптомы фарингомикоза у детей:
- затрудненное глотание;
- вялость и сонливость;
- головные боли;
- першение в горле;
- отсутствие аппетита;
- боли в животе;
- жидкий стул;
- субфебрильная температура.
Важно отметить, что многие антимикотические препараты содержат вещества, способные вызвать отравление у детей. Поэтому выбор медикаментов должен осуществляться только квалифицированным специалистом.
При наличии хотя бы нескольких из перечисленных симптомов необходимо обратиться к педиатру. Лечение детей дошкольного возраста должно проводиться исключительно под контролем врача. Если заболевание сопровождается другими патологиями, такими как кандидозный ларингит, глоссит или тонзиллит, ребенка следует госпитализировать.
Вопрос-ответ
Какие симптомы при кандидозе горла?
Локализация воспалений при кандидозе полости рта: миндалины — кандидозное воспаление миндалин сопровождается покраснением, набуханием и образованием белых пятен. Боли при глотании кандидоз не вызывает. Слизистая оболочка щёк — сопровождается покраснением и обильным выделением белой творожистой массы.
Как понять, что кашель от грибка?
Среди основных симптомов грибкового бронхита можно выделить: частые приступы кашля с отхаркиванием мокроты. Кашель при грибковом бронхите может появляться как после физических нагрузок, так и в покое. Он может быть длительным и продолжаться несколько недель или месяцев.
Советы
СОВЕТ №1
Обратите внимание на симптомы: если вы испытываете боль в горле, затрудненное глотание или белый налет на миндалинах, это может быть признаком грибковой инфекции. Не игнорируйте эти симптомы и проконсультируйтесь с врачом.
СОВЕТ №2
Следите за своим иммунитетом: поддержание здорового образа жизни, включая сбалансированное питание, регулярные физические нагрузки и достаточный сон, поможет укрепить вашу иммунную систему и снизить риск развития грибковых инфекций.
СОВЕТ №3
Избегайте самолечения: не пытайтесь лечить грибковую инфекцию самостоятельно, так как это может привести к ухудшению состояния. Обратитесь к врачу для получения точного диагноза и назначения адекватного лечения.
СОВЕТ №4
Соблюдайте гигиену полости рта: регулярная чистка зубов и использование антисептических полоскателей помогут предотвратить развитие грибковых инфекций в горле. Убедитесь, что вы используете зубную щетку, которая не содержит бактерий.